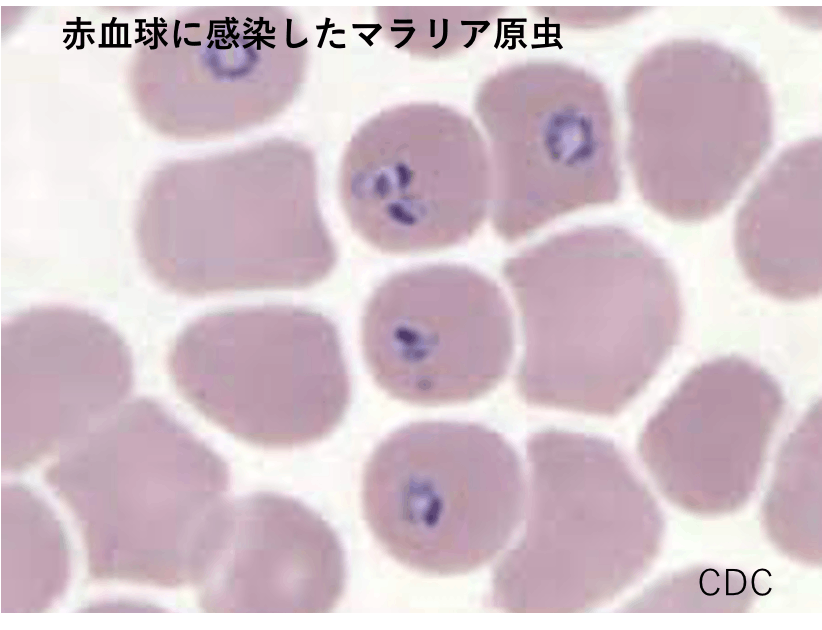

八重山のマラリアとの闘いの歴史を知っていますか?
沖縄県の南西に広がる八重山の島々は、美しく豊かな自然と独特の文化が息づき、ゆったりと流れる時間と癒しを求めて多くの人々が訪れます。
しかし、つい60年前まで、そこは、ヤキーヌシマ (マラリアの島、ヤキー=灼ける・マラリア、ヌシマ=の島)と呼ばれ恐れられてきました。

マラリアとは、マラリア原虫という寄生虫が感染することによる病気です。ハマダラカという蚊がマラリア原虫を運び、血を吸うときに人の体内に侵入します。高熱と異常な寒気が特徴です。中でもジャングルの渓流で発生する蚊が運ぶ熱帯熱マラリアは致死率が非常に高く、大変恐ろしい感染症です。
この感染症の歴史は古く、エジプトのミイラからマラリア原虫の遺伝子が見つかっています。長い歴史にもかかわらず、蚊と原虫と人との戦いは続いており、未だ世界では年間40万人以上が亡くなっています。(WHO Malaria Report 2019)

八重山では400年以上もの間、マラリアは人々の命を脅かすだけではなく、村自体を廃村においこむなど、社会経済活動の最も大きな障害でした。先の第2次世界大戦では、日本軍はマラリアの巣窟であったジャングルに八重山住民を強制疎開させ、人口の約2分の1の16,000人以上がマラリアに罹患し、3,647名が戦闘ではなくマラリアにより命を落とす、戦争マラリアの惨禍を経験しました。
戦後もマラリアの流行は続きました。当時、八重山は米軍統治下にあり、経済的にも困窮した中、人々はマラリアと戦わなければなりませんでした。
保健所職員による脾腫(マラリアの症状の一つ)の検診風景
その時々の情勢と政治に翻弄されながらも、八重山には科学に基づいたマラリア対策、科学者リーダーたちの意思決定と政策、GHQと保健行政と住民の連携がありました。
そして、1962年ついにマラリアは八重山から一掃されました。そこには、感染症時代を乗り越えるための教訓があります。
壁に貼られたマラリア患者数
1962年以降ゼロが並ぶ
今年、八重山でゼロマラリアを達成してから60周年の節目を迎えます。
1960年頃の石垣島のこどもたち
奇しくも我々は、現在新型コロナウイルス感染症の世界的大流行に直面し、感染症のない世界は、当たり前の世界ではないことを痛感しています。感染症と戦い、血と汗を流した多くの先人たちのおかげで、現在八重山のジャングルで多くの人々が遊び笑うことができていることを心に刻み、その物語を地域に根付かせたいのです。
2020年の石垣島のこどもたち
米軍統制下、経済的に困難な状況下にあった八重山で、400年以上続いた風土病マラリアを一掃したことは、現在もなおマラリアに苦しむ熱帯地域を中心とした国々に勇気を与えます。
チーム代表・斉藤が担当したJICA沖縄感染症コースの研修員ら、沖縄の小学生と一緒にボウフラ調査
私たち「Team Yaeyama Zero Malaria」は、八重山マラリアゼロマラリア60周年を迎えるにあたり、八重山の小さな島々で繰り広げられたゼロマラリア達成という偉業を再評価し、後世に伝承し、感染症を生き抜くための教訓を世界に発信するために、「ゼロマラリア伝えようプロジェクト」を開始しました。本プロジェクトで石垣市伊野田に住民と関係者で建立する「ゼロマラリア」石碑の説明板を設置します。
地域に暮らす人々が誇りとし、また、高齢化したおじいおばあの悲惨な戦争マラリアの体験を昇華する 一助になってほしいと祈っています。
西表島を臨む 波照間島の海
***このプロジェクトで実現したいこと***
Team Yaeyama Zero Malaria は、2022年八重山のゼロマラリア達成から60周年 を迎えるにあたり、ゼロマラリアの碑の「説明版」を設置し、伊野田公民館へ無償譲渡する予定です。また、この説明板をとおして、先人たちの偉業を、地域に根付かせ、後世に、そして世界に伝えていきたいと思っています。
この活動は、琉球大学の社会貢献活動の一つとして位置付け、研究成果の地域還元を行うものです。
ゼロマラリアまでの道のりと、地域(伊野田)との関わりについて記した説明板(900x1800 mm 予定)を、ゼロマラリア達成直前まで対策を続けた石垣市伊野田集落の公民館の敷地に設置予定です。
八重山の地区住民と関係者は、ゼロマラリアの碑建立期成会を発足させ、石碑建立に向け始動しました。我々は石碑と説明板を世界モスキートディ(8月20日)に同時にお披露目しようと張り切っています。
住民説明会の様子とメディアの取材
***現在進行中の記念事業***
我々はすでに記念事業を開始しています。
■4カ国版デジタルサイト「八重山のマラリア史」の公開 (https://arcg.is/1y0qHC)

■講演会活動
チーム代表斉藤による宜野湾市博物館での市民公開講座
■小学校での特別授業
八重山の小学校での特別授業 ボウフラの観察 みんな真剣!
小学生のみなさんからの珠玉の感想文集
■八重山のマラリア対策の歴史絵本の作成
絵本作成にむけて会議中
■石垣島の人々によるゼロマラリアの碑建立期成会の応援
Team Yaeyama Zero Malaria は研究教育の面から石碑建立を応援しています。
期成会の方達と協力し、一緒に、8月20日世界モスキートディお披露目を目指しています。
「達成の碑」8月建立へ マラリア撲滅60年で期成会
1月30日付八重山毎日新聞
https://www.y-mainichi.co.jp/news/38167/
石碑設置予定地の伊野田公民館に突如現れた!べニア板の碑!
上記の活動を行いながら、さらに八重山という小さな島々で繰り広げられた世界に誇れる歴史を未来につなげていきたいと思っています。
***実施スケジュール***
-プロジェクトの実施スケジュール-
■4月 伊野田地区住民と話し合い
設計及び、説明板作成開始
■5月 絵本「八重山のマラリア」(仮題)リターンイベント順次開催
■6月 特別授業・講演会(予定)
(新型コロナ感染症の状況次第で、延期もしくはオンライン開催への変更あり)
■7月 基礎工事 説明板印刷 設置準備
■8月20日 世界モスキートディに説明板設置 講演会 お披露目
(新型コロナ感染症の状況次第で、講演会はオンライン開催への変更あり)
***リターン***
おすすめリターンの紹介
■ 「応援ありがとうございます!」感謝のサンクスメールをお届けします。
■ 八重山の小学5年生に限定無料配布予定の絵本「八重山のマラリア」(仮題)
絵本(現物)は郵送で、PDF版はメールでお届けします。
■ プロジェクトが終了しましたら、報告メールをお届けします。
応援することを楽しんで頂けるように、活動内容を随時アップしていきます。
また、リターンの更新もしていく予定です!
■TeamYaeyamaZeroMalaria缶バッジをリターンに追加しました!
***資金の使い道***
■石碑説明版設置:120万円
石垣市伊野田地区公民館に設置予定の素敵な石碑の横に、ゼロマラリアまでの道のりと、地域との関わりについて記した説明板を設置します。
(説明板印刷費・60万円、設計費・30万円、基礎工事費・30万円)
■人件費 旅費:90万円
石垣島の北部に位置する伊野田地区は、おじいおばあが頑張っている地域です。また、石垣市街から遠く、通信も不安定で、遠隔の会議はできません。設置やお披露目会の準備など、感染対策バッチリして、沖縄本島から、石垣まで飛んで、住民の方達と直接話してくるための旅費が必要です。
また、teamで頑張っていますが、クラウドファンディング対応とそのプロジェクトに人が必要です。
(人件費・45万円、スタッフ旅費・45万円)
■説明会・講演会・特別授業:35万円
八重山地方で一般向け、学校向けの八重山のマラリアの歴史を講演会や特別授業でお話しします。
また、伊野田地区で、クラウドファンディング終了後、詳細な説明会を開きます。
(会場費・15万円、会議準備費・10万円 特別授業準備費・10万円)
■リターン費用・クラウドファンディング手数料等 55万円
(クラウドファンディング手数料・27万円、琉球大学間接経費・15万円 リターン・13万円)
寄付が300万円に届かなかった場合
このプロジェクトで石碑説明板設置は必ず実施します。
優先順位① 説明会・石碑説明板設置費と設置及び準備にかかる人件費・旅費にあてる予定です。
その際、寄付金額により、説明板と枠の質や大きさなどを調整する可能性があります。
優先順位② 寄付金額によって特別授業と講演会の規模、回数、方法、学校数を調整します。
リターンは全て実施いたします。
<募集方式について>
本プロジェクトはAll-in方式で実施します。目標金額に満たない場合も、計画を実行し、リターンを
お届けします。また、このプロジェクトへのご寄付は寄付金控除の対象になります。
「寄付金控除」をお受けいただくためには、確定申告の際に、琉球大学が発行した領収証をもって
確定申告をしていただく必要がございます。(領収証の発行は、5月の予定となります)
※領収証はCAMPFIREではなく琉球大学が発行・郵送いたします。
***賛同者のみなさま***
【私たちも応援しています】
■伊野田前公民館長/ゼロマラリアの碑建立期成会 会長 仲原清正
■ゼロマラリアの碑建立期成会 事務局長 島村賢正
■八重山戦争マラリアを語り継ぐ会 会長 江川義久
■八重山戦争マラリア遺族会 会長 唐眞盛充
■忘勿石之碑修復・波照間島戦争マラリア犠牲者戦没者慰霊之碑建立期成会 会長 内原勲
■ジャーナリスト・竹富町史編集委員・元石垣市史編集委員長 三木健
■石垣市伊野田オートキャンプ場管理者 Value Creation CEO 嘉数博仁
■琉球大学・大学院・保健学研究科長/教授 小林潤
■琉球大学人文社会学部 教授 豊見山和行
■琉球大学博物館(風樹館) 学芸員 佐々木健志
■国立国際医療研究センター研究所 熱帯医学・マラリア部長/日本熱帯医学会前理事長 狩野繁之
■認定NPO法人Malaria No More Japan 理事 長島美紀
■青山学院大学文学部 教授/感染症アーカイブズ代表 (感染症の歴史学) 飯島渉
■京都大学学際融合教育研究推進センター 特定教授 吉川みな子
■酪農学園大学教授/NPO 北海道市民環境ネットワーク理事長 金子正美
これから賛同者やメッセージを随時更新する予定です。
***支援のお願い***
戦争や災害による土地利用の変化、食糧不足による森林開拓、地球温暖化、人々や物の移動のグローバル化にともない新興再興感染症出現の繰り返しが現実のものとなり、これからの感染症時代を覚悟しなければならなりません。
我々は今、歴史に学ぶ必要があります。この忘れられた八重山の感染症との戦いの歴史を、ぜひ表舞台に立たせてください。
ご支援よろしくお願いいたします。
**プロジェクトへの意気込み**
Team Yaeyama Zero Malariaは、琉球大学の有志で結成された、学際的なteamです。楽しく真面目に真剣に「ゼロマラリア伝えようプロジェクト」に取り組んでいます。
コロナ禍の今、先人たち一人一人が何を考えて、何を感じて、マラリアと闘ってきたのか、輪郭を持ってきました。一方、当時を知る人、語れる人が高齢化し、昨今極端に少なくなってきています。この機を逃すと地域に根ざした伝承が難しくなるとの危機感を抱いています。
今だから伝えなくっちゃ。今だから残さなくっちゃ。と意気込んでいます。是非我々に伝承のお手伝いをさせて下さい。
ゼロマラリア達成時、保健所職員の方達が咽び泣き、歓喜したように、我々も八重山の方達と美酒を交わしたい、、、のです。
Team Yaeyama Zero Malaria代表 斉藤美加
Teamメンバーととガジャン君(と集まれなかった人たちも一緒に)
張り切ってクラファン挑戦中
最新の活動報告
もっと見る
ゼロマラリア賞授賞をはじめ嬉しいニュースが盛りだくさんの近況報告です!
2023/07/18 14:28猛暑が続いておりますが、みなさまお元気にお過ごしでしょうか?先月6月23日は、戦後78年目の慰霊の日でした。沖縄では、慰霊の日を迎える6月は、県内各地、教育現場でも平和について考える平和教育の取り組みが多く行われます。今年は、八重山以外でも八重山のマラリアに関する記事や報道が多く!私たちの取り組みのおかげかも…(゚∀゚)と密かに喜んでおります!なかでもトップニュースは、八重山ゼロマラリア達成の碑建立期成会のゼロマラリア賞授賞です!ゼロマラリア賞とは、特定非営利活動法人マラリア・ノーモア・ジャパンから、2030年までにゼロマラリアを達成するという国際社会の目標に寄与する活動に取り組む個人・団体を表彰するものです。ゼロマラリア賞の授与式は、6月20日、伊野田公民館隣の農村公園広場内で行われ、八重山ゼロマラリア達成の碑建立期成会の仲原会長は「これからもゼロマラリア賞の趣旨を広め、世界からマラリアを一掃すべく、活動を展開していく」と話されていました。同法人からは「新たな感染症の時代と言われる今、石碑建立と活動の意義は大きい」との評価をいただきました!本当におめでとうございます!・ゼロマラリア賞を授与 特定非営利活動法人 八重山毎日新聞https://www.y-mainichi.co.jp/news/39600・八重山のマラリア根絶の歴史 伝える活動を表彰 沖縄テレビhttps://news.yahoo.co.jp/articles/cb18b56b187661418d497f210bada70a8760fad2・ゼロマラリア賞授賞式開催 マラリア・ノーモア・ジャパンHPhttps://malarianomore.jp/archives/13538また、マラリア根絶への取り組みが行われていた当時に歌われていた「マラリア撲滅の歌」復活のニュースも!・「マラリア撲滅の歌」復活へ|NHK 沖縄県のニュースhttps://www3.nhk.or.jp/lnews/okinawa/20230629/5090023844.htmlそして、子供たちに平和教育を行う小・中学校の先生方への特別講座も開催することができました![戦後78年]マラリアの悲劇 疑似体験 石垣 教員向け平和講座 歴史継承 学び深める 沖縄タイムスhttps://www.okinawatimes.co.jp/articles/-/1183801ここでは、一昨年、石垣市の八島小学校でも行った戦争マラリアのシュミレーションゲームを通してのグループワークを実践。ワークの実践中は静かな先生方も、共有の時間になると、いろいろな意見が飛び交い、大いに盛り上がりました!「実際に授業で活用したい」という先生も!とても楽しく、また課題も教えて頂き、有意義な時間となりました!ありがとうございました。 もっと見る
4月25日は世界マラリアの日!嬉しいニュースが盛りだくさんでした!!
2023/04/26 12:50絵本「ヤキーヌシマの物語」ついに公開!そして、八重山ゼロマラリア達成の碑建立期成会がゼロマラリア賞受賞決定!昨日、4月25日は、世界マラリアの日でした!この日にあわせて、絵本「ヤキーヌシマの物語-八重山からマラリアがなくなるまで」を公開しました。下記のURLからホームページにアクセスすると、無料ダウンロードの手順が記載されています。どうぞご覧ください。https://yakiinushima.wixsite.com/gajanまた、昨日アップされた朝日新聞のwith planetには、戦争マラリアの特集記事が掲載されています。ここでは、斉藤のコメント、また絵本公開についても記載されています。https://www.asahi.com/withplanet/stg/article/2023042501.htmlさらに…!!!第10回ゼロマラリア賞が、八重山ゼロマラリア達成の碑建立期成会へ贈られることが、決定しました!https://malarianomore.jp/archives/13434マラリア・ノーモアジャパンのHPでは、絵本の公開についても掲載されています!絵本で描いた八重山の先人たちの感染症との闘いから、今、自分に何ができるのかを考えるきっかけになればと願っています。たくさんの方々に読んでいただければ嬉しいです。 もっと見る
ついに実現!八重山ゼロマラリア達成の碑にてJICA研修が行われました
2023/02/02 11:53八重山のゼロマラリア達成の歴史を世界へ発信!今、マラリアと闘っている地域の方々に、八重山のゼロマラリア達成の歴史を伝えたい!ずっと目指してきた我々Teamの目標がやっと達成しました!1月26日、27日で沖縄JICA感染症コースの研修会が、石垣市で行われ、27日は、伊野田へ!八重山ゼロマラリア達成の碑の下マラリア根絶の歴史を学びました。ここでは、我々がみなさまとともに作成した多言語版説明板が大活躍しました。その模様は、NHK沖縄、八重山毎日新聞でも紹介されました!https://www3.nhk.or.jp/lnews/okinawa/20230127/5090021744.html 【2023.1.28 八重山毎日新聞 転載許可済】八重山ゼロマラリア達成の碑期成会の方々は、ご自身の体験談を話してくださり、研修生は、住民の方達の話を直接伺う貴重な機会に恵まれ、学びの多い時間となりました。また代表の斉藤は講演を行い、クライマックスは仲原会長の三線の生演奏でカチャーシーも!大盛況の研修会となりました! もっと見る





コメント
もっと見る